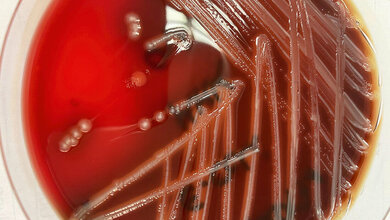
Hämolysierender E. coli auf Blutagar

Neuen Auslöser für Antibiotikaresistenzen gefunden?
Eine neue Studie von Rutgers Health hat gezeigt, dass Ciprofloxacin, ein Standardmedikament gegen Harnwegsinfektionen, Escherichia coli (E. coli) in eine Energiekrise stürzt, die viele Zellen vor dem Tod bewahrt und damit offenbar die Entwicklung von Resistenzen beschleunigen kann. Die Wissenschaftlerinnen und Wissenschaftler wollten testen, wie sich die Veränderungen des bakteriellen Metabolismus auf die Überlebenschancen der Bakterien auswirken. Sie konzentrierten sich auf Adenosintriphosphat (ATP), den molekularen Brennstoff, der Zellen antreibt. Sinkt der ATP-Spiegel, erfahren Zellen „bioenergetischen Stress“. Um diesen Stress zu simulieren, veränderte das Team E. coli so, dass sie ständig ATP oder dessen Verwandten Nicotinamidadenindinukleotid (NADH) verbrannten. Anschließend setzten sie sowohl die veränderten Stämme als auch normale Bakterien Ciprofloxacin aus.
Rolle der persistierenden Zellen
Die Ergebnisse waren überraschend. Sowohl das Medikament als auch die genetischen Veränderungen haben den ATP-Spiegel drastisch reduziert, doch anstatt sich zu verlangsamen, haben die Bakterien ihre Aktivität beschleunigt. Die Zellen stießen zusätzliche reaktive Sauerstoffmoleküle aus, die die DNA schädigen können. In Time-Kill-Tests überstanden zehnmal so viele gestresste Zellen eine tödliche Ciprofloxacin-Dosis wie unbelastete Kontrollzellen. Diese widerstandsfähigen Nachzügler, die sogenannten persistierenden Zellen, bleiben unauffällig, bis das Medikament aufgebraucht ist, und lösen dann eine neue Infektion aus. Lange Zeit wurde ein träger Stoffwechsel für die Bildung persistierender Zellen verantwortlich gemacht. Man habe erwartet, dass ein langsamerer Stoffwechsel weniger Abtötungen verursache, sagte Barry Li, einer der Autoren. Das Gegenteil sei beobachtet worden. Die Zellen steigerten ihren Stoffwechsel, um ihre Energiereserven wieder aufzufüllen, und das habe Stressreaktionen ausgelöst, die die Abtötung verlangsamten.
Mutierte gestresste Zellen entwickelten Antibiotikaresistenzen
Die Rutgers-Gruppe setzte E. coli steigenden Ciprofloxacin-Dosen aus und stellte fest, dass gestresste Zellen die Resistenzschwelle vier Runden früher erreichten als normale Zellen. DNA-Sequenzierung und klassische Mutationstests deuteten auf oxidative Schäden und fehleranfällige Reparaturmechanismen als Ursache hin. Die Veränderungen im Stoffwechsel hätten dazu geführt, dass Antibiotika weniger wirksam seien und Bakterien Resistenzen entwickelten, sagte Jason Yang, Assistenzprofessor an der Medizinischen Fakultät und Kanzler-Stipendiat für Mikrobiologie, Biochemie und Molekulargenetik. Vorläufige Messungen haben gezeigt, dass neben Ciprofloxacin auch Gentamicin und Ampicillin ATP verbrauchen. Der Stresseffekt könnte sich auf sehr unterschiedliche Krankheitserreger erstrecken, darunter auch auf den Erreger Mycobacterium tuberculosis, der hochempfindlich auf ATP-Schocks reagiere.
Veränderungen bei Antibiotika und Behandlung nötig?
Falls dies zutreffe, werfe die Entdeckung ein neues Licht auf eine globale Bedrohung, so das Forschungsteam. Antibiotikaresistenzen tragen bereits zu 1,27 Millionen Todesfällen pro Jahr bei. Strategien, die die metabolischen Folgen der Behandlung ignorieren, könnten einen wichtigen Hebel übersehen. Die Ergebnisse legen verschiedene Änderungen für die Entwicklung und Anwendung von Antibiotika nahe. Zunächst sollten Antibiotikakandidaten auf unbeabsichtigte, energieverbrauchende Nebenwirkungen untersucht werden. Zweitens sollten bestehende Medikamente mit „Anti-Evolutions-Boostern“ kombiniert werden, die die Stresswege blockieren oder die überschüssigen Sauerstoffradikale eliminieren. Drittens sollte überdacht werden, ob Infektionen mit der höchstmöglichen Dosis bekämpft werden sollen. Frühere Studien und die neuen Daten deuteten darauf hin, dass extreme Konzentrationen genau den Stress auslösen können, der Bakterien schützt. Li und Yang planen, Wirkstoffe zu testen, die bioenergetischen Stress lindern, in der Hoffnung, die mikrobielle Energiekrise wieder zu einer Achillesferse statt zu einem Schutzschild zu machen.
Quelle: Rutgers Health
Artikel teilen